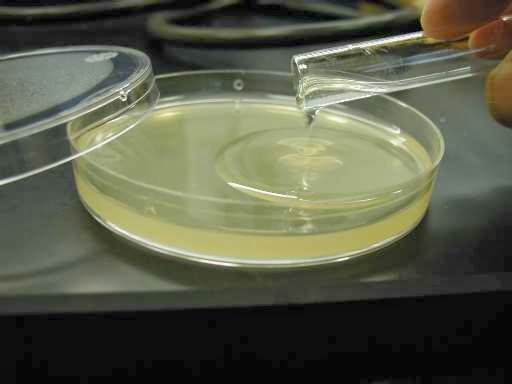

As vidrarias de laboratório são um símbolo para a ciência, algo exclusivo de ambientes laboratoriais, auxiliam nos experimentos realizado pelos profissionais ou estudantes para estudos, pesquisas, trabalhos, e por todos aqueles que necessitam deste utensílio.
As vidrarias são as ferramentas mais utilizadas em um ambiente laboratorial, tanto em um laboratório de química quanto em um de biologia.
Existe uma imensa variedade de vidros que são utilizados em ambientes laboratoriais, são utilizados para realizar experimentos e estudos, fazendo testes, misturas e reações químicas, cada um tendo sua perspectiva função e finalidade.
Os vidros geralmente são feitos de vidro comum ou vidro temperado, podendo ser feito também de quartzo fundido ou vidro pirex, quando o vidro tem função de ser aquecido em altas temperaturas, precisam ser feitos de um material mais resistente.
Confira as vidrarias mais utilizadas e suas respectivas funções:
Tubo de ensaio

O tubo de ensaio é um dos vidros mais comuns e utilizados em um ambiente laboratorial, ele é utilizado para aquecer substâncias em baixas temperaturas e para testar reações, mas podendo ter diversas finalidades, como, armazenar o cultivo de colônias de bactérias ou fungos, e outros organismos.
BAlão de destilação

São usados para armazenar uma mistura no processo de destilação. A substância durante o processo, tem seus gases separados do meio líquido, e estes gases se direcionam à saída lateral, que é acoplada em um condensador, onde passaram por outros processos.
BAlão volumétrico

Utilizado para preparar soluções ou diluições que necessitam de medidas extremamente precisas, pois, possui uma graduação volumétrica com alta precisão. Mas o volume é único e fixo, sendo descrito na parte externa do balão.
Bastão de vidro

Este vidro possui um aspecto de haste e é utilizado para homogeneizar ou agitar soluções, já que não reage quimicamente. Utilizado também para direcionar um líquido na transferência de um recipiente para outro.
Bureta

São utilizados para medir e transferir os líquidos, pois, é possível controlar o escoamento da substância através de uma torneira, permitindo ser um escoamento rápido ou por gotejamento.
Becker de vidro

Este vidro também é muito comum e de uso geral, utilizado para medir substâncias que não necessitam de precisam, e possui um bico que facilita a transferência da substância de um recipiente para outro.
lâminas e lamínulas

São pequenos quadrados de vidros, utilizados para colocar amostras de uma substância, organismo ou qualquer material que queira observar e analisar microscopicamente. São mais comuns no laboratório de biologia.
pipetas

Pipeta graduada 
Pipeta volumétrica
A pipeta é utilizada para medir e transferir pequenos volumes de líquidos, existem dois tipos de pipeta, a pipeta graduada e a volumétrica.
A pipeta graduada possui graduações ao longo do seu tubo, podendo medir volumes variáveis. Enquanto a pipeta volumétrica possui um volume fixo, tendo uma precisão maior. Nenhuma pipeta pode ser aquecida.
placa de petri
São mais usadas em laboratórios de biologia para desenvolver meios de cultura bacteriológicos ou outros organismos, como fungos, para observar a germinação das plantas e de grãos de pólen ou o comportamento de pequenos animais. Nos laboratórios de química, são utilizadas para reações em escala reduzida e também para deixar repousar cristais e filtrados.
proveta

Utilizada para medição e transferência de volumes de líquidos ou soluções com menor precisão que as pipetas. Possui uma graduação no tubo de vidro, para marcação volumétrica comportado pelo vidro.


Um comentário em “Vidrarias de Laboratório – Parte 1”